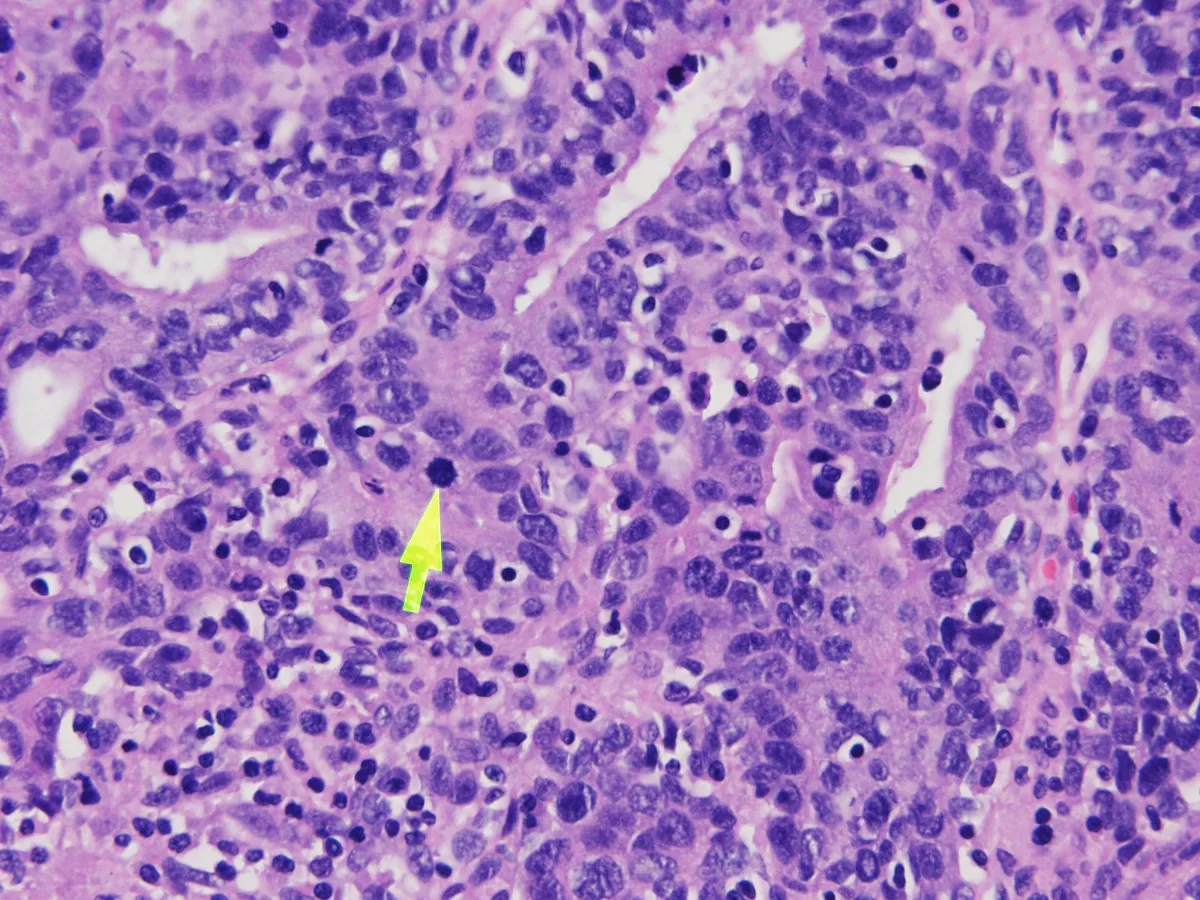

Enhorabuena a Eugenia Isabel Ortega Pinto, residente de 3º año del Hospital Universitario 12 de Octubre, por ser la autora de nuestro CASO DEL MES de JUNIO 2025.
DESCRIPCIÓN DEL CASO:
Hombre de 37 años de edad que acude a urgencias por tumoración flogótica, de aspecto quístico, de 1,6x1cm a nivel cara cubital del 5º dedo mano izquierda, la cual se reseca.
Imágenes:
¿Cuál es tu diagnóstico?
El diagnóstico y los aspectos esenciales de esta entidad se encuentran a continuación…
Diagnóstico: Adenocarcinoma papilar digital.
Aspectos esenciales:
- El adenocarcinoma papilar digital (APD) es una neoplasia rara y agresiva de las glándulas sudoríparas. (PMID: 34532052)
- Los dedos de las manos se ven afectadas con mayor frecuencia (representan >80% de los casos), aunque también se pueden ubicar en otras áreas acrales. (PMID: 35538210)
- Se han notificado casos raros en sitios no acrales. (PMID: 27428196)
- La mayoría de los tumores se presentan como una lesión solitaria, nodular, de crecimiento lento y aspecto quístico. (PMID: 34532052)
- Presenta una incidencia de 0,08 por 1.000.000 de personas-año. (PMID: 29578881)
- La etiología de esta entidad está asociada al VPH 42. (PMID: 35538210)
- Histológicamente, el APD es un tumor multinodular, bien circunscrito, que presenta patrones de crecimiento sólido, quístico y papilar. (PMID: 32002453)
- La característica típica son glándulas fusionadas o papilas verdaderas, constituidas por células epiteliales cúbicas o columnares, que ocasionalmente muestran secreción apocrina, con zonas revestidas por una capa periférica de células mioepiteliales. (PMID: 23026931)
- El grado de atipia citológica, el índice mitótico y la presencia de necrosis es variable entre casos. (PMID: 23026931)
- Las células tumorales son difusamente positivas para pancitoqueratina y CK7. EMA y CEA tiñen el componente epitelial. Mientras, p63 y podoplanina (D2-40) tiñen las células mioepiteliales. (PMID: 23026931)
- Las tasas de recurrencia local y metástasis son del 26 al 50%, respectivamente, según algunos autores. También, se ha reportado invasión linfovascular. (PMID: 23026931)
DESCRIPCIÓN DEL CASO:
Hombre de 37 años de edad que acude a urgencias por tumoración flogótica, de aspecto quístico, de 1,6x1cm a nivel cara cubital del 5º dedo mano izquierda, la cual se reseca.
Imágenes:

1- Panoramica

2- Panoramica2

3- HE

4- HE
5- Mitosis

6- Mitosis 2

7- MIB-1

8- EMA

9- p63

10- Invasión vascular
¿Cuál es tu diagnóstico?
El diagnóstico y los aspectos esenciales de esta entidad se encuentran a continuación…
Diagnóstico: Adenocarcinoma papilar digital.
Aspectos esenciales:
- El adenocarcinoma papilar digital (APD) es una neoplasia rara y agresiva de las glándulas sudoríparas. (PMID: 34532052)
- Los dedos de las manos se ven afectadas con mayor frecuencia (representan >80% de los casos), aunque también se pueden ubicar en otras áreas acrales. (PMID: 35538210)
- Se han notificado casos raros en sitios no acrales. (PMID: 27428196)
- La mayoría de los tumores se presentan como una lesión solitaria, nodular, de crecimiento lento y aspecto quístico. (PMID: 34532052)
- Presenta una incidencia de 0,08 por 1.000.000 de personas-año. (PMID: 29578881)
- La etiología de esta entidad está asociada al VPH 42. (PMID: 35538210)
- Histológicamente, el APD es un tumor multinodular, bien circunscrito, que presenta patrones de crecimiento sólido, quístico y papilar. (PMID: 32002453)
- La característica típica son glándulas fusionadas o papilas verdaderas, constituidas por células epiteliales cúbicas o columnares, que ocasionalmente muestran secreción apocrina, con zonas revestidas por una capa periférica de células mioepiteliales. (PMID: 23026931)
- El grado de atipia citológica, el índice mitótico y la presencia de necrosis es variable entre casos. (PMID: 23026931)
- Las células tumorales son difusamente positivas para pancitoqueratina y CK7. EMA y CEA tiñen el componente epitelial. Mientras, p63 y podoplanina (D2-40) tiñen las células mioepiteliales. (PMID: 23026931)
- Las tasas de recurrencia local y metástasis son del 26 al 50%, respectivamente, según algunos autores. También, se ha reportado invasión linfovascular. (PMID: 23026931)

